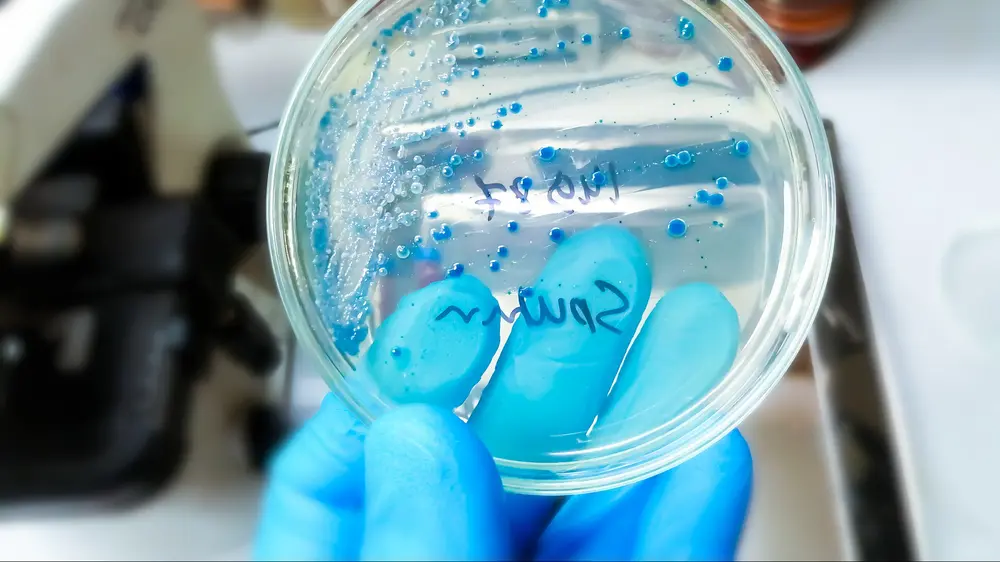

16/12/2025
Met de campagne Iedereen ambassadeur zet het Vlaams Apothekersnetwerk (VAN) het laagdrempelige karakter van de apotheek in de kijker.

16/12/2025
Dat heeft de artsenvakbond British Medical Association (BMA) meegedeeld. De staking komt er op een moment dat het Verenigd Koninkrijk getroffen wordt door een zogenaamde "supergriep".

15/12/2025
Het biomedisch onderzoeksinstituut BIOMED UHasselt krijgt een beurs van 300.000 euro van Stichting Stop Alzheimer om te onderzoeken of een enzym dat een belangrijke rol speelt in de ontwikkeling van MS ook impact heeft op Alzheimer.

15/12/2025
De Kamercommissie Gezondheid stemde vandaag unaniem in met een wetsvoorstel dat een aantal heffingen voor farmaceutische bedrijven verlengt in 2026. In totaal levert dat de gezondheidszorgbegroting 600 miljoen euro op, zegt indiener Jan Bertels.

15/12/2025
Een nieuw onderzoek waarschuwt dat gebrekkige transparantieregels binnen de EU de tabaksindustrie toelaten om in stilte invloed uit te oefenen op het beleid in Brussel.

15/12/2025
De commissie Binnenlandse Zaken keurde op 12 december het wetsontwerp over de weerbaarheid van kritieke entiteiten goed. Het moet nog door de plenaire Kamer worden bekrachtigd.

15/12/2025
Niet alle bevolkingsgroepen werden even hard getroffen door de COVID-19-pandemie. Dat blijkt uit het HELICON-project waarvan de resultaten vandaag worden voorgesteld.

15/12/2025
Het Antigifcentrum waarschuwt zaterdag voor het gebruik van illegale vapes, nadat verschillende jongeren na het gebruik ervan in het ziekenhuis zijn beland in Antwerpen.

12/12/2025
Het Verenigd Koninkrijk krijgt dezer dagen te maken met een "ongeziene golf van een supergriep". Daarvoor heeft de Britse gezondheidsdienst gewaarschuwd, enkele dagen voor een vijfdaagse staking van Britse dokters gepland staat.

12/12/2025
Minister van Volksgezondheid Frank Vandenbroucke (Vooruit) heeft de Europese Commissie in een brief gevraagd om werk te maken van een Europees register van voor donoren van sperma en eicellen, en een limiet op het aantal kinderen per donor.

11/12/2025
“Nu blijkt dat ziekenfondsen bijzonder winstgevende bedrijven zijn die ver afgedreven zijn van hun kerntaken, is het tijd om in te grijpen”, zegt N-VA-kamerlid Frieda Gijbels. “Wat is hun meerwaarde, behalve diegene die ze voor zichzelf genereren?”

11/12/2025
Minister van Volksgezondheid Frank Vandenbroucke (Vooruit) wil niet weten van een degradatie van de ziekenfondsen als uitbetalers van de verplichte ziekteverzekering.

11/12/2025
Om de inkrimping met 25% van de budgetten voor internationale samenwerking te counteren, richten acht ngo’s die actief zijn in de gezondheidssector vandaag de Health Impact Coalition op.

11/12/2025
Rode Kruis-Vlaanderen heeft in het Mariaziekenhuis Noorderhart in Pelt de eerste plasmadonorclub gelanceerd. Het nieuwe concept is meteen een primeur in Vlaanderen en de derde Limburgse locatie waar plasma gegeven kan worden.

10/12/2025
In de Kamercommissie Gezondheid stelde minister van Volksgezondheid Frank Vandenbroucke dat het RIZIV sterkere wapens nodig heeft om fraude aan te pakken, maar dat dat niet betekent dat iedere zorgverstrekker verdacht wordt.

10/12/2025
De Deense spermadonor met een ernstige genmutatie, heeft verspreid over Europa, minstens 197 kinderen verwekt. In ons land zouden 53 kinderen zijn verwekt met het zaad van de donor.

9/12/2025
De zaak startte op 16 januari 2020, nadat een man aangifte had gedaan tegen de huisdokter.
9/12/2025
Volksvertegenwoordigers Kathleen Depoorter c.s. (N-VA) dienden bij de Kamer van Volksvertegenwoordigers een voorstel van resolutie in ‘strekkende tot een alomvattende vaccinatie tegen pneumokokkeninfecties.

9/12/2025
De herziening van de Europese geneesmiddelenwetgeving, waarover de Europese Unie morgen vergadert, zou verstrekkende gevolgen kunnen hebben voor de beschikbaarheid van essentiële geneesmiddelen in België en de EU.

8/12/2025
In Engeland is bij een persoon die onlangs naar Azië is gereisd een nieuwe mpox-variant ontdekt. Dat meldt het Britse gezondheidsagentschap UKHSA maandag.